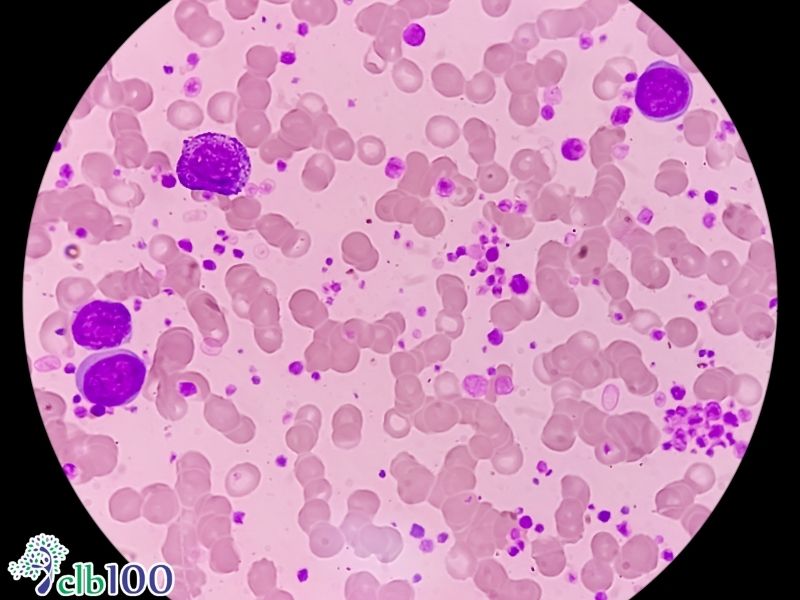
Nhiệm vụ của tế bào B và tế bào T

Hãy quan sát kỹ những
cặp sinh đôi cùng trứng. Về mặt thị giác, họ giống hệt nhau như hai giọt nước, chia sẻ chung một nụ cười, màu da và vóc dáng. Sự tương đồng tuyệt đối này khiến nhiều người, kể cả trong giới y khoa trước đây,
lầm tưởng rằng
họ chia sẻ chung một hệ miễn dịch bảo vệ cơ thể. Vậy sự thật thì sinh đôi cùng trứng có hệ miễn dịch giống hệt nhau không?
Câu trả lời chính xác nhất là:
KHÔNG.
Khả năng miễn dịch không phải là một chương trình phần mềm được cài đặt cố định từ lúc lọt lòng. Theo dữ liệu y khoa rào cản phòng vệ của cơ thể được định hình và tinh chỉnh liên tục bởi những gì mỗi cá nhân tiếp xúc thực tế trong suốt cuộc đời.
Để tiềm hiểu sâu hơn về nhận định trên, hãy cùng tìm hiểu qua bài viết dưới đây của
CLB100, sẽ đóng vai trò như một góc nhìn kết hợp giữa khoa học sinh học và triết lý của thực dưỡng hiện đại, giúp bạn giải mã sự khác biệt miễn dịch này, đồng thời hướng dẫn cách tạo một hệ miễn dịch khỏe mạnh thông qua phương pháp thực dưỡng hiện đại.
Sinh đôi cùng trứng hình thành như thế nào?
Sinh đôi cùng trứng (monozygotic twins) xuất hiện khi một quả trứng duy nhất được thụ tinh bởi một tinh trùng, tạo thành một hợp tử. Trong giai đoạn phân bào rất sớm, hợp tử này đột ngột tách làm hai phôi thai và tiếp tục phát triển thành hai cá thể độc lập.
- Bộ mã di truyền (DNA): Vì xuất phát từ cùng một hợp tử, hai em bé chia sẻ 100% bộ gen di truyền gốc.
- Đặc điểm ngoại hình: Họ luôn cùng giới tính, có màu mắt, cấu trúc khuôn mặt và nhóm máu giống hệt nhau.
- Môi trường thai kỳ: Thông thường, họ chia sẻ chung một nhau thai nhưng nằm trong hai túi ối riêng biệt.
Tuy nhiên,
thiết kế DNA giống nhau chỉ quy định hình hài vật lý bên ngoài. Khi hệ thống sinh lý nội môi bắt đầu vận hành và tương tác với môi trường bên ngoài, những cỗ máy sinh học này sẽ tự động rẽ sang hai hướng hoàn toàn độc lập.

Giải đáp sinh đôi cùng trứng có hệ miễn dịch giống hệt nhau không?
Khoa học hiện đại đã chứng minh, sở hữu chung một bộ DNA không đồng nghĩa với việc sở hữu chung một hệ miễn dịch. Sự khác biệt này được lý giải bằng một nhánh khoa học đột phá mang tên
ngoại di truyền học (Epigenetics).
Ngoại di truyền học không nghiên cứu sự thay đổi trong trình tự của các chuỗi DNA, mà tập trung vào các công tắc sinh hóa điều chỉnh cách các gen này biểu hiện (Bật/Tắt). Hiện tượng này gọi là sự trôi dạt biểu sinh. Dù mang bộ mã gốc y hệt nhau, nhưng qua từng năm tháng, môi trường sống, hệ vi sinh, và thức ăn đưa vào cơ thể sẽ liên tục tác động và tái định hình mô hình methyl hóa DNA của mỗi người, khiến cấu hình miễn dịch của hai cá thể ngày càng phân kỳ rõ rệt.

Cơ chế của hệ miễn dịch cá nhân
Để hiểu vì sao môi trường lại tác động mạnh đến vậy, chúng ta cần đi sâu vào cơ chế vi mô của hệ miễn dịch. Nhiệm vụ sống còn của hệ miễn dịch là phải phân biệt được đâu là tế bào của bản thân và đâu là mầm bệnh có hại.
Mỗi tế bào trong cơ thể chúng ta đều mang các nhóm phân tử protein đặc trưng trên bề mặt để hệ miễn dịch nhận diện và chấp nhận. Ngược lại, các vi khuẩn, virus hay tế bào lạ mang trên mình những kháng nguyên có hình dạng cấu trúc không gian đặc trưng gọi là quyết định kháng nguyên. Khi cơ thể phát hiện ra các Epitope lạ này, một chuỗi phản ứng sinh hóa dữ dội sẽ được kích hoạt để đánh dấu và tiêu diệt chúng ngay lập tức. Quá trình nhận diện này phụ thuộc hoàn toàn vào những chủng vi khuẩn mà mỗi người vô tình tiếp xúc hàng ngày, tạo ra một thư viện kháng nguyên riêng biệt cho mỗi cá nhân.

Nhiệm vụ của tế bào B và tế bào T
Thực thi nhiệm vụ tiêu diệt mầm bệnh là đội quân tế bào bạch cầu, trong đó mạnh nhất là tế bào lympho B và tế bào lympho T. Quá trình hình thành và trưởng thành của các tế bào này là một minh chứng cho sự độc bản của mỗi cơ thể:
- Tế bào B: Sinh ra và trưởng thành trong tủy xương. Chúng tạo ra các kháng thể hòa tan để tìm diệt mầm bệnh từ xa. Những tế bào B nào liên kết nhầm với protein của mình sẽ ngay lập tức bị ép chết rụng.
- Tế bào T: Sinh ra từ tủy xương nhưng phải di chuyển đến tuyến ức (một tuyến bạch huyết trước tim) để được huấn luyện. Nhiệm vụ của chúng là kiểm tra an toàn gắt gao bề mặt tế bào và tiêu diệt trực tiếp tế bào nhiễm bệnh.
Sự thật: Các thụ thể trên màng tế bào miễn dịch được tạo ra một cách ngẫu nhiên. Do đó, theo ghi nhận y khoa chỉ có
2% số tế bào T hoàn thành nhiệm vụ tại tuyến ức. 98% số còn lại bị tiêu diệt tàn nhẫn vì chúng trượt bài kiểm tra và mang nguy cơ tự tấn công chính cơ thể chủ! Hệ thống chọn lọc ngẫu nhiên này khẳng định rằng kho kháng thể của mỗi người sinh đôi là một thứ không thể sao chép.
Bằng chứng khoa học về sự khác biệt miễn dịch ở cặp song sinh
Để củng cố thêm nguyên lý ngoại di truyền, nền y học thế giới đã ghi nhận hàng loạt các bằng chứng lâm sàng thực tế, chứng minh tính cá thể hóa tuyệt đối của hệ phòng vệ.
Nghiên cứu về bệnh tự miễn
Bệnh tự miễn xảy ra khi hệ thống miễn dịch bị rối loạn, tự sản xuất kháng thể tấn công nhầm vào mô khỏe mạnh của chính mình.
Một nghiên cứu đột phá từ khoa sau đại học của Đại học Osaka trên 23 cặp sinh đôi cùng trứng đã phát hiện hiện tượng bất đồng hợp tử cực kỳ rõ nét. Dù bộ gen giống hệt nhau, nhưng sự khác biệt trong mô hình methyl hóa tại các vị trí phân tử CpG trên nhiễm sắc thể đã khiến một cá thể sản xuất kháng thể tự miễn dịch tuyến giáp (mắc bệnh
viêm tuyến giáp Hashimoto hoặc
Grave), trong khi cá thể còn lại hoàn toàn khỏe mạnh.

Sự tương thích nhóm máu và hiện tượng đào thải nội tạng
Sự nhạy cảm của hệ miễn dịch còn được thể hiện rõ rệt qua hệ thống
nhóm máu ABO,
Rhesus và
hiện tượng cấy ghép tạng.
Hồng cầu của mỗi nhóm máu mang kháng nguyên đặc trưng trên bề mặt và chứa kháng thể chống lại nhóm máu khác trong huyết tương. Bất kỳ sự tiếp xúc nhầm lẫn nào đều kích hoạt phản ứng đông máu. Cơ chế này càng khốc liệt hơn trong cấy ghép nội tạng. Hệ miễn dịch được lập trình để tấn công bất cứ mô lạ nào xâm nhập. Người nhận tạng thường phải sử dụng
thuốc ức chế miễn dịch (immunosuppressants) suốt đời để làm suy yếu hệ miễn dịch của chính mình nhằm giữ lại khối tạng ghép, minh chứng cho sự bất khả xâm phạm của hàng rào miễn dịch cá nhân.

Yếu tố môi trường nào đã làm sai lệch hệ thống phòng vệ?
Dựa trên nghiên cứu kéo dài nhiều thập kỷ của Giáo sư Mark Davis (Đại học Stanford), các nhà khoa học kết luận rằng di truyền chỉ đóng vai trò thứ yếu khi chúng ta già đi. Những yếu tố môi trường đã âm thầm viết lại phần mềm miễn dịch của các cặp sinh đôi bao gồm:
- Chế độ dinh dưỡng: Thức ăn quyết định cấu trúc hệ vi sinh vật đường ruột – nơi tập trung 70% tế bào miễn dịch.
- Độc tố và môi trường sống: Không khí hít thở, nguồn nước, và đặc thù nghề nghiệp tạo ra các dạng phơi nhiễm hóa chất khác nhau.
- Căng thẳng thần kinh (Stress): Tâm lý ấu thơ, áp lực công việc làm tăng sinh cortisol, gây ức chế sản sinh tế bào lympho.
- Tiền sử bệnh lý: Những đợt cảm cúm, nhiễm trùng, hay số lần sử dụng thuốc kháng sinh đã tạo ra các tế bào nhớ miễn dịch hoàn toàn khác biệt ở hai người.
Giải pháp từ thực dưỡng hiện đại
Khi hiểu rằng hệ miễn dịch là một thực thể độc bản và có khả năng định hình lại qua môi trường, bạn sẽ nhận ra không có một phác đồ y khoa nào rập khuôn chữa bách bệnh. Đây chính là nguyên lý cốt lõi của thực dưỡng hiện đại mà CLB100 đang muốn truyền đạt đến mọi người.
Theo lối sống thuận tự nhiên không phải là một phương pháp trị bệnh cục bộ, mà là một chương trình thanh lọc cơ thể suốt đời bằng thức ăn, tạo ra một dung môi nội môi hoàn hảo nhất để kích hoạt cơ chế tự chữa lành tự nhiên.
Nguyên tắc nuôi dưỡng vi sinh vật đường ruột theo câu số 5
Hệ vi sinh vật đường ruột tổng hợp ra các axit béo chuỗi ngắn giúp điều hòa tế bào lympho T, ngăn chặn phản ứng viêm quá mức. Để nuôi dưỡng chúng, bạn cần áp dụng nghiêm ngặt bộ tài liệu 33 câu hỏi đáp thực dưỡng:
- Tuyệt đối tránh câu số 3: Đây là nhóm thực phẩm phá vỡ cấu trúc miễn dịch, bao gồm đường tinh luyện, hóa chất tạo màu, đồ hộp, và đặc biệt là hạn chế tối đa các loại thịt đỏ (heo, bò) do chúng tạo ra lượng lớn acid uric gây quá tải gan thận.
- Ưu tiên ăn theo câu số 5: Bao gồm cơm gạo lứt, váng cháo 7 thành phần, kết hợp với các siêu thực phẩm có tính kháng viêm mạnh như tía tô, củ sen, ngưu bàng, tóc tiên. Sự kết hợp này giúp duy trì pH máu ở mức kiềm nhẹ, cô lập mầm bệnh.
Lưu ý: Những người áp dụng chế độ ăn thiên thực vật cực đoan rất dễ rơi vào tình trạng thiếu máu nguyên bào khổng lồ do thiếu hụt
Vitamin B12. Để hệ thần kinh không suy nhược, người thực hành bắt buộc phải chủ động bổ sung nguồn B12 tự nhiên từ rong biển, tảo đại dương, hoặc ăn các sinh vật biển nhỏ nguyên con (cá con, tép con) nhằm kiến tạo hồng cầu vững chắc.

7 bước thực hành lối sống thuận tự nhiên
- Hít thở không khí biển: Đưa ion âm vào phổi giúp trung hòa các gốc tự do mang điện tích dương, làm giảm stress oxy hóa cấp độ tế bào.
- Đi chân trần trên cát: Là liệu pháp tiếp đất, xả bỏ sự tích tụ tĩnh điện gây viêm nhiễm và làm dịu hệ thần kinh giao cảm.
- Tắm nắng: Tia UVB kích hoạt cơ thể tự tổng hợp hormone Vitamin D3 tự nhiên – chất xúc tác sinh tử cho tế bào T hoạt động.
- Tắm cát: Dùng nhiệt lượng và khoáng chất biển để giãn nở lỗ chân lông, hút kim loại nặng và độc tố từ sâu trong cơ quan nội tạng ra ngoài.
- Thiền cầu nguyện, tĩnh tâm có định hướng: Đưa sóng não về trạng thái Alpha thư giãn, triệt tiêu hormone stress Cortisol, chống ức chế miễn dịch.
- Áp dụng thực dưỡng hiện đại: Tránh ăn câu số 3, ăn theo câu số 5 để tái tạo vật chất tế bào tinh khiết.
- Dùng trợ phương: Bổ sung các chiết xuất thảo dược hữu cơ để hỗ trợ trực tiếp các tạng phủ đang suy yếu trầm trọng.
Tầm quan trọng của việc kiểm tra y khoa định kỳ
Thực dưỡng hiện đại mang tính giới hạn về chu kỳ thời gian sinh học. Quá trình thanh lọc máu cần 20 ngày, nhưng phải mất 3 năm để thay đổi mô tế bào, và đến 7 năm để toàn bộ hệ thống tủy xương (nơi sinh ra bạch cầu) được thay mới hoàn toàn.
Hơn nữa, thực dưỡng phụ thuộc vào cảm nhận cá nhân và hoàn toàn thiếu vắng máy móc định lượng. Do đó, để đảm bảo an toàn tuyệt đối, bạn bắt buộc phải đi xét nghiệm sinh hóa y khoa định kỳ mỗi 3 đến 6 tháng. Việc kiểm tra các chỉ số máu, tổng phân tích nước tiểu, rà soát chức năng gan thận và đo mật độ loãng xương là tấm gương phản chiếu trung thực nhất. Nó giúp bạn đánh giá xem chế độ ăn của mình đã thực sự phù hợp chưa để kịp thời tinh chỉnh. Đặc biệt, trong các trường hợp cấp cứu đe dọa sinh mệnh (chấn thương, vi khuẩn độc lực cao), việc can thiệp bằng y học hiện đại là bắt buộc không thể chối từ.
Câu trả lời cho câu hỏi
Sinh đôi cùng trứng có hệ miễn dịch giống hệt nhau không? đã mang đến một sự phát hiện vĩ đại về mặt y học. DNA do cha mẹ trao tặng chỉ là bản phác thảo ban đầu; còn chính môi trường sống, bữa ăn hàng ngày và sự tĩnh tại trong tâm hồn mới là họa sĩ hoàn thiện nên bức tranh sinh mệnh của bạn.
Không có định mệnh di truyền nào là không thể thay đổi. Hãy chủ động áp dụng
7 bước lối sống thuận tự nhiên và kết nối cùng cộng đồng CLB100 để tự trang bị kiến thức, biến mình thành vị bác sĩ tốt nhất bảo vệ sức khỏe cho chính bản thân và gia đình ngay từ hôm nay.
Thông tin trên bài viết này chỉ mang tính chất tham khảo, không được xem là tư vấn y khoa và không nhằm mục đích thay thế cho tư vấn, chẩn đoán hoặc điều trị từ nhân viên y tế chuyên trách. Khi có bất kỳ dấu hiệu bất thường nào về sức khỏe, người bệnh cần đến thăm khám trực tiếp tại cơ sở y tế gần nhất, tuyệt đối không tự ý thay đổi chế độ ăn một cách đột ngột mà không có sự đồng ý của nhân viên y tế để tránh ảnh hưởng xấu đến sức khoẻ.
=> Xem thêm: Cha mẹ sinh con - Trời sinh tính: Liệu có đúng?
=> Xem thêm: Tổng hợp video nói về bệnh sinh lý và con cái của Lương y Trần Ngọc Tài
=> Xem thêm: Có thể thay đổi hệ vi sinh đường ruột khỏe mạnh hơn không?